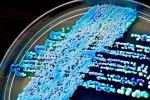
Causas de candidiasis

Tipos de candidiasis

Por: David Saceda Corralo
Médico Interno Residente, especialista en Dermatología Medicoquirúrgica y Veneorología
Por: Dr. José Antonio Nuevo González
Especialista en Medicina Interna. Servicio de Urgencias del Hospital Gregorio Marañón de Madrid
Actualizado: 22 de septiembre de 2022
Estos son los tipos de candidiasis existentes y sus síntomas asociados. Conoce dónde pueden localizarse y sus características principales:
Candidiasis superficiales
Candidiasis en la piel
Intertrigo candidiásico
La Candida aprovecha áreas de la piel húmedas y maceradas debido al roce continuo para anidar en más proporción. Las zonas más frecuentes donde surge infección es en los grandes pliegues, como los interglúteos, las ingles, las axilas y bajo las mamas; y los pliegues abdominales en personas obesas. También ocurre en pequeños pliegues, como los que hay entre los dedos de las manos y de los pies; y en el caso de los recién nacidos, las Candidas favorecen el “eccema del pañal”.
Comienza con picor y pústulas que aumentan de tamaño hasta romperse, dejando una piel roja y brillante en los dos lados del pliegue. El fondo del pliegue suele fisurarse y toda la lesión produce una sensación de calor.

Onixis y perionixis candidiósica
Es la infección por Candidas de la uña y sus inserciones, frecuente en personas que tienen las manos húmedas por su ocupación (por ejemplo, lavanderas). Se inicia con inflamación de la inserción de la uña con dolor, enrojecimiento e hinchazón, al apretar se puede ver la salida de pus desde la inserción. Después se puede afectar la uña produciéndose una pérdida de su color y alteraciones de su forma.
Candidiasis en la boca
Muguet oral
El muguet oral es la infección más frecuente por Candida, ocurre con más frecuencia en los lactantes y personas con alguna alteración del sistema inmune. Se forman placas blanquecinas que cubren la mucosa oral como una membrana; al despegarlas dejan una superficie roja y sangrante. Puede no dar síntomas o producir escozor e incluso dolor que aumenta al comer.
Candidiasis oral atrófica
Es poco frecuente, aparece más en personas de edad avanzada. Se caracteriza por una zonas de destrucción de la mucosa oral que presentan color rojizo.
Queilitis angular
Inflamación de las comisuras bucales, casi siempre de las dos a la vez. Las comisuras se fisuran y alrededor de ellas aparece un área muy enrojecida con vesículas que se rompen y escuecen. Este tipo de lesiones también aparecen en déficit de vitaminas B, prótesis dentales mal colocadas y exceso de salivación.

Candidiasis en el aparato reproductor
Vulvovaginitis candidiósica
La inflamación de la vulva y la vagina debido a infección por Candidas aparece con bastante frecuencia en mujeres con alteraciones de su pH vaginal, hecho que se da especialmente en embarazadas. Se caracteriza por un picor vulvar intenso y que persiste con el rascado; la vulva y la vagina tienen un aspecto congestivo y rojizo debido a la irritación. A veces aparecen placas blanquecinas en la mucosa, y siempre hay aumento del flujo vaginal, que puede ser líquido o espeso y blanquecino.
Balanitis candidósica
En los hombres, la Candida puede causar infección del glande y el prepucio del pene. Comienza con pequeñas vesículas y pústulas que causan picor y escozor; poco a poco se rompen y aparecen lesiones irritativas más o menos extensas (limitadas al glande o hasta ingles y escroto). Normalmente, la balanitis candidósica en un varón sano con buena higiene no debe durar más de tres o cinco días; si dura más el paciente es sospechoso de padecer diabetes, alteraciones del sistema inmune, o estar en tratamiento con antibióticos. Si los episodios de balanitis candidiósica se repiten y son cortos es probable que sea la pareja sexual la que continúe infectada aunque no tenga síntomas.
Candidiasis profundas
Candidiasis en el aparato digestivo
Candidiasis esofágica
La afectación del esófago causa una inflamación del mismo, que provoca dificultad de la deglución, sensación de ardor y dolor en el tórax, por lo que se puede confundir con un infarto de corazón. En los niños, el esófago se suele afectar por extensión del muguet oral, y en los adultos podemos encontrar esta infección en casos de SIDA, tratamiento con antibióticos, diabetes, cáncer, tratamientos crónicos con omeprazol, etcétera.
Gastritis candidiósica
La afectación del estómago es poco frecuente, solo ocurre en casos muy avanzados de infecciones diseminadas por la sangre, si bien es cierto que es más frecuente en pacientes con úlcera gástrica. Es posible que el uso de omeprazol y otros inhibidores de la secreción ácida favorezcan la colonización de Candidas.
Enteritis candidósica
La infección del intestino suele asociarse a tratamiento con antibióticos en niños pequeños, pero solo ocurre en muy raras ocasiones. Aparece dolor abdominal, heces frecuentes y líquidas de color marrón claro o amarillo, a veces con hilos de sangre. Su principal complicación es la deshidratación por la diarrea, además su diagnóstico temprano no es fácil.
Anitis candidiósica
El ano se irrita y aparece picor, su superficie externa se erosiona provocando escozor, y frecuentemente la infección se extiende provocando un intertrigo cutáneo.
Candidiasis en el sistema respiratorio
Laringitis candidósica
Suele ser secundario a un muguet oral y provoca afonía. En una exploración otorrinolaringológica, como la fibroscopia, se pueden ver las placas blanquecinas típicas del muguet. En ocasiones puede haber afectación de los bronquios, que cursa con tos frecuente, fiebre y esputos con sangre.
Candidiasis en el aparato excretor
Candiduria
La presencia de Candidas en orina suele ocurrir en enfermos hospitalizados con sonda, diabéticos y en aquellos tratados con antibióticos. Puede no dar síntomas o aparecer cistitis, inflamación de la vejiga, con fiebre y escozor al orinar. Un análisis de orina con Candidas no indica definitivamente infección, pues ocurre en muchas personas sanas.

Otros tipos de de candidiasis
Endocarditis candidósica
Cuando las Candidas llegan a la sangre alcanzan las válvulas del corazón, y pueden invadirlas formando grandes vegetaciones. Este tipo de infección (endocarditis candidósica) es más frecuente en pacientes con catéteres infectados, y también en consumidores de heroína u otras drogas por vía parenteral, especialmente si la droga es adulterada o si se diluye en zumo de limón, ya que la Candida anida en ese cítrico. Las vegetaciones de Candidas en las válvulas cardíacas pueden desprender émbolos infectados, que viajan por las grandes arterias hasta que ocluyen arterias más pequeñas produciendo infartos.
Candidiasis mucocutánea crónica
Esta enfermedad se ha relacionado con diferentes enfermedades endocrinológicas (hipoparatiroidismo, hipotiroidismo, hipocorticoadrenalismo…) e inmunológicas (agammaglobulinemias, síndrome de Di George). Suele iniciarse en la infancia con un muguet oral que persiste tras el tratamiento adecuado; más tarde se suelen afectar piel, uñas, cabellos y las mucosas. La enfermedad evoluciona con el tiempo hacia la formación de granulomas deformantes, surgiendo verdaderas “bolas” en los dedos, por ejemplo. También es frecuente la pérdida de cabello para siempre y el estrechamiento del esófago. Los enfermos viven muchos años y suelen morir por infecciones bacterianas secundarias.

Candidiasis invasora
Se define así la forma en la que el hongo llega al torrente sanguíneo provocando una infección generalizada y pudiendo asentar en los distintos órganos del cuerpo. Esta situación se denomina candidemia, y es la manifestación más grave de la infección, conllevando una alta mortalidad.
Suele originarse por la infección de catéteres que se insertan en personas hospitalizadas y con algún tipo de alteración de su sistema inmunitario, pudiendo provocar infecciones de órganos vitales.
Creado: 21 de julio de 2010